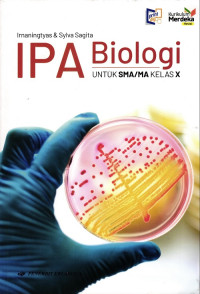
Image of IPA Biologi 10

Text
IPA Biologi 10
Buku IPA Biologi SMA ini ditujukan bagi peserta didik yang ingin memahami biologi secara lebih mendalam.
Ketersediaan
#
My Library (SMA)
570 IRN i
B1906844
Tersedia
Informasi Detail
- Judul Seri
-
-
- No. Panggil
-
570 IRN i
- Penerbit
- JAKARTA : Quadra., 2021
- Deskripsi Fisik
-
342 hlm,; 25 cm
- Bahasa
-
Indonesia
- ISBN/ISSN
-
9786231807878
- Klasifikasi
-
570
- Tipe Isi
-
text
- Tipe Media
-
-
- Tipe Pembawa
-
-
- Edisi
-
-
- Subjek
- Info Detail Spesifik
-
SMA kelas X
- Pernyataan Tanggungjawab
-
Kurikulum Merdeka
Versi lain/terkait
Tidak tersedia versi lain
Lampiran Berkas
Tidak Ada Data
Komentar
Anda harus masuk sebelum memberikan komentar
 Karya Umum
Karya Umum  Filsafat
Filsafat  Agama
Agama  Ilmu-ilmu Sosial
Ilmu-ilmu Sosial  Bahasa
Bahasa  Ilmu-ilmu Murni
Ilmu-ilmu Murni  Ilmu-ilmu Terapan
Ilmu-ilmu Terapan  Kesenian, Hiburan, dan Olahraga
Kesenian, Hiburan, dan Olahraga  Kesusastraan
Kesusastraan  Geografi dan Sejarah
Geografi dan Sejarah